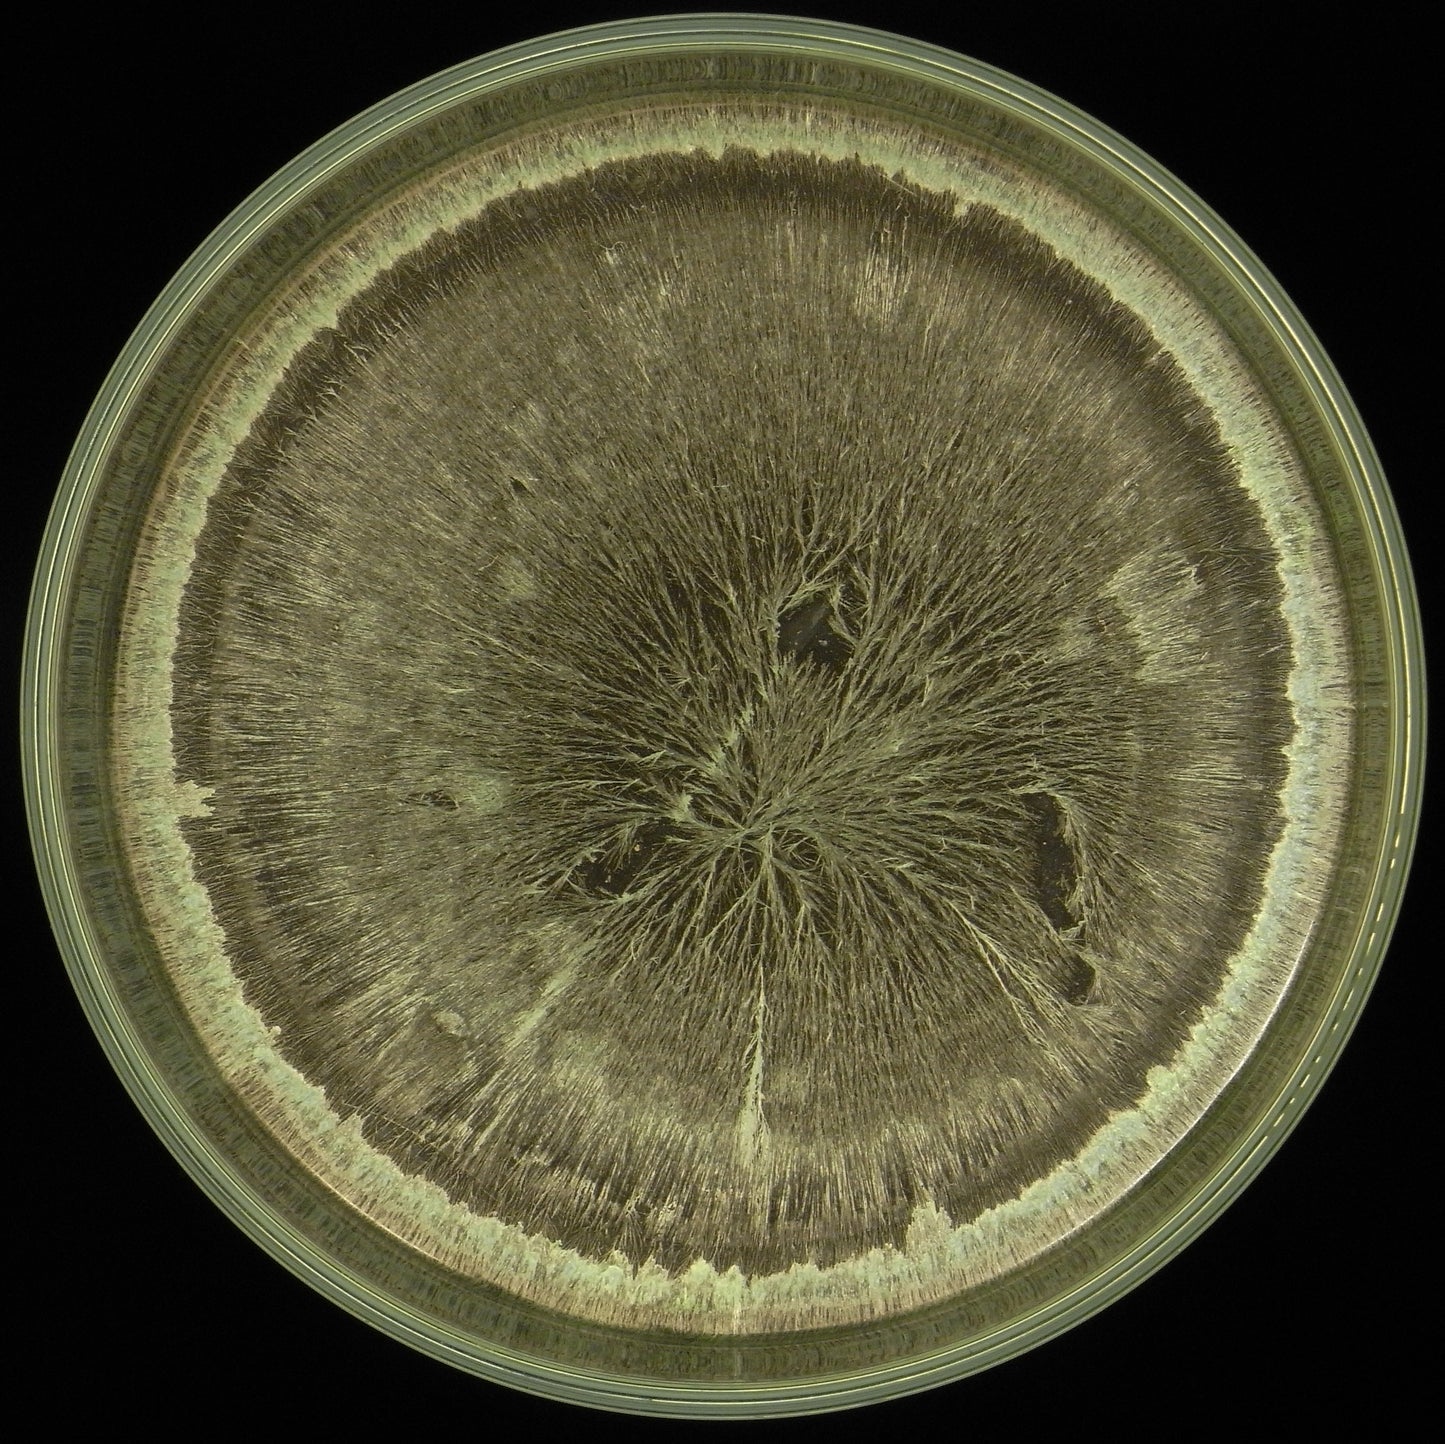

500 CORNOLETAME DI CAVALLA
Have a question?

500 CORNOLETAME DI CAVALLA
Dettagli
I PREPARATI BIODINAMICI
IL 500 CORNOLETAME DI CAVALLA
Che cos’è:
E’ letame fresco di cavalla compostato ed interrato in un corno di mucca da S. Michele a Pasqua e che si presenta quando si dissotterra come humus, inodore, fresco, umido e colloidale. R. Steiner dice durante il Corso di Koberwitz che si possono usare anche altri letami di ruminanti come il cavallo e spiega anche come fare per sopperire alla mancanza del corno, usando i crini della cavalla mescolati con letame nel corno di una vacca. Tende ad asciugare più del 500 classico ed ad essere più fibroso: mantenerlo sempre umido.
A cosa serve:
è uno “lievito” dei processi vitali della terra, può essere considerato un attivatore della formazione dell’humus e della radicazione delle piante.
Utile per terreni molto freddi e calcarei: porta processi di calore ed attira esseri elementari dell’aria e del calore.
Utile per indurre nel terreno resistenza alla siccità
Utile per piante a legno molto vecchie
modalità di uso:
• il 500 oviene usato alle dosi di 200 gr/35 – 50 lt H2O non clorata/ ettaro
• è consigliato usare il 500 almeno 2 volte in primavera ed una in autunno
• da dinamizzare e spruzzare per ogni nuova semina
• la temperatura dell’acqua deve essere tiepida (da 37° a 40°)
• l’acqua non deve essere riscaldata da corrente elettrica ma con legna od a gas
• l’acqua deve essere preferibilmente piovana o di pozzo o di fonte (non ristagnante da troppo tempo, senza odori o presenza di lave etc.)
• se proprio devo usare acqua di acquedotto deve essere agitata e lasciare all’aria aperta a decantare per almeno 24 ore
• è sconsigliabile l’acqua ferruginosa o quella con elevato quantitativo di calcio od acque salate
• il 500 viene attivato per mezzo di un particolare mescolamento che si chiama dinamizzazione che dura 60 minuti (vedi scheda sul sito)
• la dinamizzazione consiste nel mescolare il 500 in acqua, creando un vortice che a sua volta viene interrotto da una fase di caos, coincidente con l’inversione della direzione del vortice precedente.
• La dinamizzazione può essere effettuata sia a macchina che manualmente:
1) a mano purchè effettuata con molta energia e senza soste
2) a macchina purchè vengano rispettate alcune caratteristiche di costruzione, come ad es. l’inversione del vortice che deve essere regolata dalla fluidità dell’acqua e non da temporizzatori, e che il vortice sia creato partendo dall’alto
• La botte per la dinamizzazione deve avere una forma cilindrica che possa consentire un profondo vertice conico
• La presenza di lombrichi nel cornoletame è un ottimo segno di vitalità
• La dinamizzazione va fatta a goccia grossa sul terreno e sul legno di sera
• Il sacchetto di plastica serve solo per il trasporto, il preparato per la conservazione va trasferito in un vasetto di vetro o di metallo e conservato nell’apposita cassetta dei preparati se non lo si usa nel giro di una settimana.
• Il preparato 500 lo trovate pronto presso Agri.Bio : lo spediamo in tutta Italia ed all’estero
• Agri.Bio organizza ogni anno corsi per insegnare gratuitamente l’allestimento e l’uso dei preparati biodinamici: vedi sito www.agribionotizie.it : L’Agricoltura del Domani